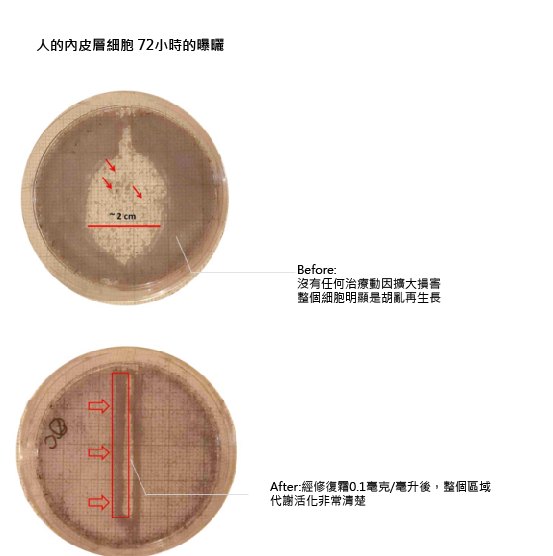

反時光修護霜
2019-09-10
反時光修復霜適用於受損、暗沉、壓力和疲倦的肌膚,能舒緩肌膚的壓力和不適感。
各個年齡層的男女皆適用,使用後能增強肌膚的保護力,達到潤膚、 保濕及保護的作用,並使肌膚由內而外恢復光澤亮麗。

商品描述
- 舒緩乾燥不適、壓力以及疲倦的肌膚。
- 維持肌膚水潤柔順,讓氣色看起來亮麗飽滿。
- 能幫助肌膚抵禦環境的傷害,增強肌膚的保護能力。
- 先進的保存技術,不含對羥基苯甲酸酯(化妝品及藥品工業中的防腐劑)、過敏原和著色劑。

使用方法
適合早晚及日常保養,使用於化妝水-精華液後。
為了獲得最佳效果,建議在早上和晚上徹底清潔後,取適量修復霜於指尖上,平均塗抹在需改善部位的肌膚上,順著肌膚紋路按摩至吸收。
避免強烈陽光造成肌膚受損,白天須進行紫外線防護, 請搭配使用防曬產品。
容量 : 50ml
定價:NT.8,480
製造廠:CHOLLEY / 瑞士
進口/總代理:新沛企業股份有限公司